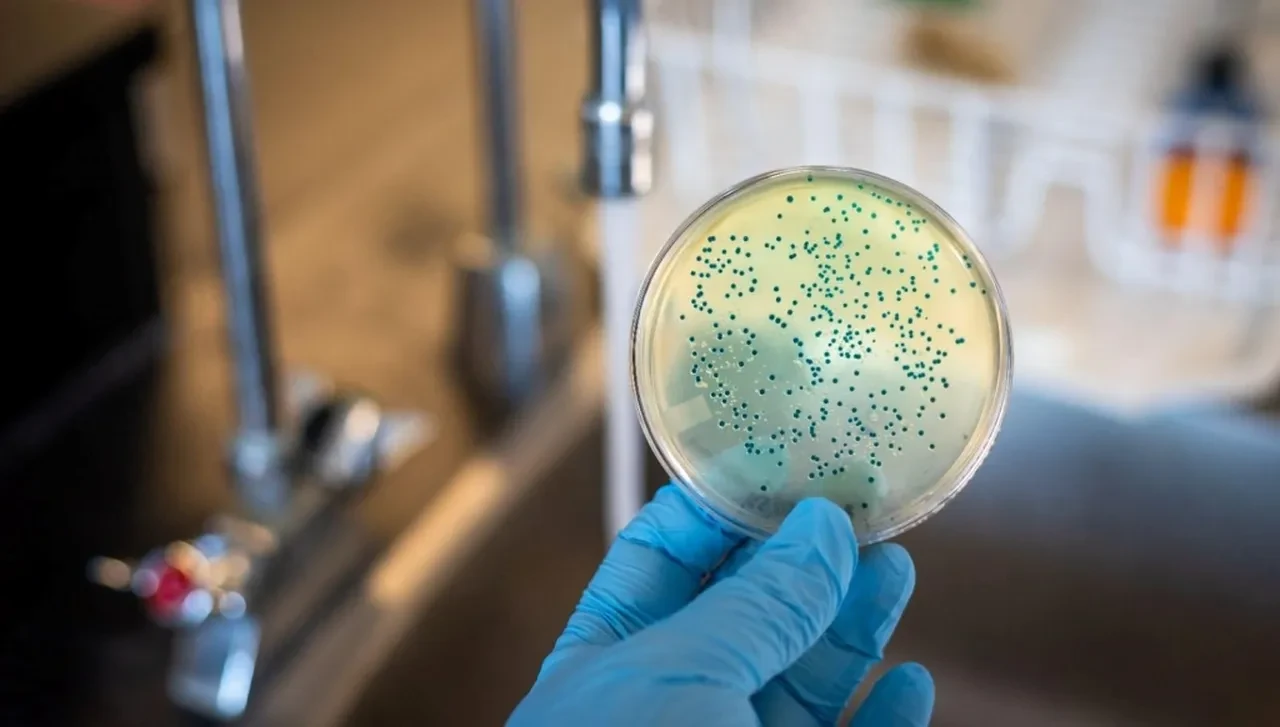
Hastanelerin yeni kâbusu keşfedildi! Tıbbi cihazları adeta yiyip bitiriyor

Kategoriler
UYGULAMALAR
İstanbul

İngiltere'de Sheffield Üniversitesi ve Birmingham Üniversitesi'nden bilim insanları tarafından yapılan bir araştırmada, dünya çapında her yıl yaklaşık 559 bin kişinin ölümüne neden olan Pseudomonas aeruginosa bakterisinin yeni bir özelliği keşfedildi.
Nature Communications dergisinde yayımlanan çalışmaya göre, bu bakteri türü, tıbbi cihazlarda yaygın olarak kullanılan belirli plastik türlerini parçalayarak enerji kaynağı olarak kullanabiliyor.
Araştırma ekibi, bir hastanın yara enfeksiyonundan alınan bakteri örneğini laboratuvar ortamında inceledi.
Deneylerde, bakterinin “Pap1” adı verilen özel bir enzim ürettiği ve bu enzim sayesinde plastikleri parçalayıp biyolojik süreçlerinde yakıt olarak kullandığı ortaya çıkarıldı. Enzim, özellikle polikarbonat ve poliüretan gibi medikal alanda sık kullanılan plastik türlerinde etkili oldu.

Pseudomonas aeruginosa bakterisi, bağışıklık sistemi ve antibiyotiklere karşı direnç geliştirmesini sağlayan biyofilm adı verilen koruyucu bir tabaka oluşturma yeteneğine sahip. Yapılan analizlerde, bakterinin plastik yüzeylerde bu biyofilmleri daha büyük, daha güçlü ve daha dirençli şekilde oluşturduğu belirlendi.

Araştırmanın baş yazarı Dr. Joanna Roberts, "Bu bakteri sadece yüzeye tutunmakla kalmıyor, aynı zamanda plastiği yapısına entegre ederek adeta bir çimento gibi kullanıyor. Bu, enfeksiyonun tedaviye karşı direncini artırıyor ve onu yok etmeyi çok daha zor hale getiriyor" dedi.

Uzmanlara göre bu bulgular, özellikle kateterler, ortopedik implantlar, yara tedavi pedleri, solunum cihazları ve hidrojel bazlı ürünler gibi plastik içeren tıbbi ekipmanların güvenliğini yeniden değerlendirme gerekliliğini ortaya koyuyor.
ABD Hastalık Kontrol ve Önleme Merkezleri (CDC) verilerine göre, Pseudomonas aeruginosa, hastanelerde edinilen enfeksiyonların en sık görülen nedenlerinden biri ve özellikle yoğun bakım hastalarında ciddi sonuçlara yol açabiliyor. CDC, bu bakteriyi “kritik tehdit” sınıfına dahil ediyor.

Science Alert ve The Guardian gibi uluslararası kaynaklar da araştırmanın sonuçlarını “endişe verici” olarak nitelendirdi.
Özellikle antibiyotik direnci çağında, plastikle beslenebilen mikroorganizmaların çoğalması, hem tıp dünyasında hem de çevresel mikrobiyoloji alanında yeni riskleri beraberinde getiriyor
The Guardian'da yer alan değerlendirmede, “Tıbbi cihazlar, bakteriler için sadece barınak değil, artık bir besin kaynağı haline geliyor olabilir. Bu durum enfeksiyon kontrol protokollerini tamamen değiştirebilir” ifadesine yer verildi.